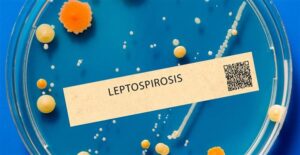

Recurrent Infections in Children – Is Immunity Low?
What Are Recurrent Infections in Children? Many parents worry when their child gets sick often. Recurrent infections in children mean your child has frequent illnesses,

What Are Recurrent Infections in Children? Many parents worry when their child gets sick often. Recurrent infections in children mean your child has frequent illnesses,

Recovering after major surgery can feel overwhelming. The first four weeks are important for healing and regaining strength. During this time, your body works hard

Introduction Uterine fibroids are non-cancerous growths that form in or on the uterus. Many women have them, but not all fibroids cause problems. However, some

What Are Kidney Stones? Kidney stones are hard lumps that form inside your kidneys. They develop when minerals and salts stick together. Often, these stones

Introduction Before any surgery, it is important to ask questions and understand what will happen. Many people think the doctor will explain everything, but you

What is Acute Pancreatitis? Acute pancreatitis is a sudden swelling of the pancreas. The pancreas is a small organ behind your stomach. It helps with

What is Dyspareunia? Dyspareunia means pain during sexual intercourse. This condition can affect both women and men, but it is more common in women. Often,
What is Leptospirosis? Leptospirosis is a bacterial infection that can affect both people and animals. It is caused by bacteria called Leptospira. Often, people get

Rheumatoid arthritis is a long-term disease that causes joint pain and swelling. It can affect people of any age, but it is more common in

Dengue fever affects millions across the world each year without fail. This illness, often called “breakbone fever,” is known for causing severe pain. Dengue is

Did you know that each year, food poisoning affects about 600 million people worldwide? This translates to almost 1 in 10 people globally! Food poisoning

Managing chronic UTI symptoms begins with understanding both what triggers them and how to effectively address these triggers. Recognizing chronic UTI symptoms is crucial in

Recognizing kidney stones symptoms early can make a huge difference. Early detection helps manage the situation better and prevents complications. Many people may not realize

Drug poisoning is a growing concern in many homes and communities. Accidentally ingesting dangerous drugs can happen to anyone, often leading to serious health risks

PCOS, short for Polycystic Ovary Syndrome, is a common health issue affecting women all over the world, including in India. About one in ten women